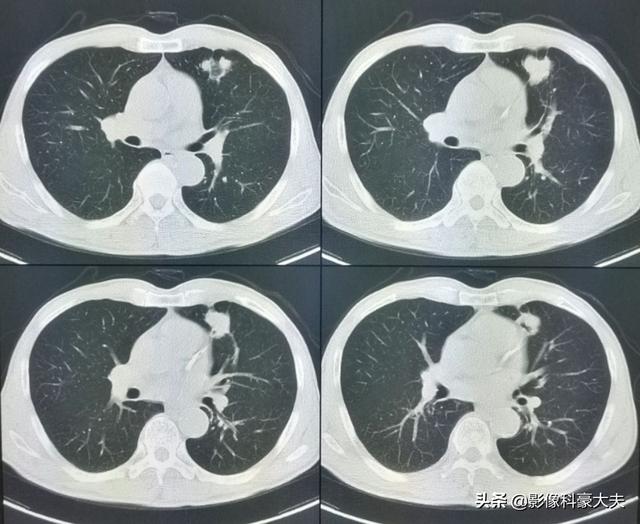

骨転移として注意すべき痛みとはどのようなものですか?
骨転移として注意すべき痛みとはどのようなものですか?
セルフケアの観点から、がんの骨転移による痛みには以下のような特徴がある。
1、まずはがん患者であること。もちろん、より悪性度の高い症例では原発巣発見前に骨転移を起こすケースもありますが、非常にまれです。ほとんどのケースは、乳がん、前立腺がんなどの原発腫瘍の既往によるものです。
2、背骨や手足などの骨の痛みによって引き起こされるいくつかの方法は、通常、筋膜炎、関節炎、骨粗しょう症などの痛みを引き起こす可能性がありますが、痛みによって引き起こされるこれらの問題は、多くの場合、ベッドレストでは、温湿布は明らかに緩和した後に表示されます。癌の骨転移による痛みの場合は、安静にしていても良くなることはありませんので、安静にしていても明らかな痛みがある場合は注意が必要です。
3、"判明したらどうするのか?"という暴論的な質問をするユーザーが少なくないようだが、"判明しない "と "判明しない "は違う。判明しないことと、判明しないことは別物であり、鎮痛の観点からすれば、原因を特定した上で、より的を絞った鎮痛対策を行うことになるし、同時に病的骨折を予防して、患者さんのQOL(生活の質)を向上させる必要がある。一方、発見できることは、発見できないことよりも治癒に近い。発見できるということは、疑わしい症例を除外できるということでもあり、がんの疑いがある患者さんの骨転移の疑いを除外できれば、それは患者さんにとって非常に重要なことです。
骨転移は多くの悪性腫瘍、特に肺がんで起こりうるが骨転移は一般的に致命的ではない。長い間生き延びることができる。
5年間生存している低分化癌の鎖骨転移
この症例は58歳のゲイ男性で、肩を軽く伸ばしただけで痛みが続くようになり、X線検査で低密度病巣が見つかった:
これは骨転移に基づく軽微な外力による病的骨折であった。穿刺が行われ、病理結果は低分化肺腺癌の骨転移であった。
左肺にあるこの不規則な結節が原発巣で、わずか2.6cmしかない。このような骨転移を伴う肺がんは、もはや手術不可能です。肺がんはあまりにもありふれた病気であり、初期症状の中には非典型的なものや無症状のものさえあるからだ。肺がんの約30%では、転移の症状が最初の症状であり、さらなる肺がんが発見される前に転移が最初に発見される。
幸いこの患者は治療に敏感で、化学療法と標的療法に基づく治療を組み合わせて5年間治療を受けてきた。
これは、当時彼が鎖骨骨折のために受けた内固定手術で、手術をしなければ自然治癒が非常に難しい病的骨折である。
直近のCT検査の結果、原発巣はかなり縮小しており、5年以上保菌したまま生きられたのは幸運だった!
骨転移を警告すべき痛みとはどのようなものですか?
率直に言って、骨転移の症状は発生部位に関連しており、強く特徴付けられるものではない。一般的な特徴は以下の通りである:夜間痛と安静時痛が優勢で、繰り返し起こり、長く続く。
とりたてて中高年、新しい背中や足の痛み、関節の痛み、さらには歯痛、短期間再発する場合は、整形外科真剣にそれをチェックし、病気の早期治療を持ってハングアップしてみてください!
この老人は、右側の歯痛と頬の膀胱の痛みで、2ヶ月以上、歯の根の炎症がある老人のように薬を服用してきたが、現在では上顎洞癌における骨破壊上へ

この患者だ。左股関節痛、大腿骨頭壊死を心配したが、肺がん骨転移と判明。
悪性新生物は過去10年間、年率3.9%で増加している。がんの発生率が高い理由を論じるつもりはない。中高年、特に腫瘍の家族歴のある人は、健康診断に注意を払うべきである!健康診断を受けられる状況でなくても、体の一部が異常なシグナルを発している場合、特に骨や関節が持続的な痛みを示し、夜間に重苦しく、鎮痛剤でも緩和されない場合は、深刻に受け止めるべきである!
画像診断のドクター・ハウです!
数日前、肺がんの骨転移の患者を診断したばかりで、彼の症状は長期的な腰背部痛で、彼らはいつも腰椎の筋肉の緊張、または腰椎椎間板ヘルニアに苦しんでいると思ったが、気にしなかった、本当に痛みが深刻で、下肢の神経症状が現れ、唯一の検査のために病院へ、そのCT検査に与えられた、明らかな椎骨破壊があることがわかった。......病歴を詳しく調べると、患者は長期的に咳の症状があるため、肺がんの骨転移が強く疑われ、肺のCT検査を行ったところ、主な焦点は......巨大な肺がんであることがわかった。

實に骨転移のような病気を診断するのは、医師として心臓に負担がかかるというのも、骨転移が起こってしまったからだ。がんが進行していることを意味する。患者の生存の可能性は著しく減少し、生存期間も短くならざるを得ないかもしれません。骨転移とは何ですか?骨転移が見つかったときにすでに骨転移があるがん患者がいるのはなぜですか?骨転移のある患者さんの痛みの症状にはどのような特徴があるのでしょうか?このことについて、楽しくおしゃべりしましょう。
骨転移
骨転移は、骨組織外に発生する特定の悪性腫瘍である。血流を通じて骨組織に移行。骨の損傷と痛みが主な症状として現れる疾患。
例えば、肺がんに罹患している患者がいたとして、肺がんはまず肺の組織にできる。肺の腫瘍細胞は元の腫瘤から分離できる。これは、血流が骨内など体内の他の部位に入り込む症状で、次のように呼ばれる。骨転移ここで重要なのは、たとえ骨にがん細胞が見つかっても、まだそこにあるということだ。ここでの重要なポイントは、たとえガン細胞が骨に見つかってもがん細胞は骨組織からではなく、肺からです。。

脊椎に発生する骨転移が最も多く(34%)、次いで骨盤(20%)、下肢の長骨(12%)。。

乳がんは骨転移を起こしやすいがんである前立腺がんは65~75%の確率で骨転移を起こし、甲状腺がんは60%の確率で骨転移を起こし、肺がんは30~40%の確率で骨転移を起こす。
また、骨転移が生じると生存期間が著しく短くなり、ある研究によると、骨転移と診断された患者の生存期間は以下の通りである。生存期間中央値賛成だ:肺がんは6~7ヵ月、膀胱がんは6~9ヵ月、腎細胞がんは12ヵ月、前立腺がんは12~53ヵ月、甲状腺がんは48ヵ月である。この生存期間中央値は、骨転移を起こしてからこの期間まで生きられる患者は50%に過ぎないと解釈できる。

骨転移患者に共通する痛みの特徴は?その他の症状にはどのようなものがありますか?
骨転移のある患者に最もよくみられる症状は、以下のようなものである。骨転移患者の最初の症状であることが多い痛みこの痛みは、患者によっては断続的で、痛いときもあれば痛くないときもあるが、徐々に悪化して長く続く。痛みは夜間に悪化する..脊椎に痛みを感じる患者もいる。この痛みは、安静にしたり横になったりしても緩和されない。.多くの患者は、初期の段階ではそれほどひどくない痛みを持っているが、時間とともに症状はどんどん重くなり、鎮痛剤では緩和されないケースもある。

骨転移は悪者の骨を弱くし、骨折につながる可能性がある。病的骨折癌による骨転移病理学的骨折を呈する患者の割合は、がん患者の10~30%である。前立腺癌から大腿骨茎に転移があった老人を診たことがあるが、彼は自宅で花に水をやっていて、振り向いたときに骨折した。痛みと機能障害。
すでに述べたとおりだ。骨転移が最も起こりやすいのは脊椎である。だから、もし移籍が決まったら、次のような可能性がある。椎体の圧迫骨折また、腫れが脊髄に達することもある。脊髄の圧迫神経根の炎症に似た症状を引き起こすことがある。下肢のしびれや痛み脊髄が圧迫された患者の中には、以下のような病気を発症するリスクがある。歩行の変化と四肢の脱力また、重度の圧迫骨折や脊髄をひどく圧迫している腫瘍がある患者には、以下のような発症リスクがある。麻痺。

骨転移の場合、より深刻な異常は以下によって引き起こされる。高钙血症これは骨から血液中にカルシウムが漏出するためである。骨転移が起こると、骨から血液中にカルシウムが漏れ出し、高カルシウム血症になり、高度の高カルシウム血症になると、患者は次のような病気になる可能性があるからだ。便秘、吐き気、食欲不振、極度の喉の渇き、頻尿、脱水症状、疲労感、最悪の場合は昏睡状態に陥る。。
以上のことを知った上で、なぜ多くのがん患者に骨転移が見つかるのかを分析してみよう。
実際、その主な理由は、身体に症状がある患者の多くが採用された言葉はひとつ。。
冒頭で謝医師がこの症例を紹介したように、彼は長い間痛みを感じていたが、それを気にせず、ずっと腰椎椎間板ヘルニアか腰椎筋緊張症だと思っていて、病院で診断を受けることもなく、医療専門家に相談することもなく、長期化する中でがんが転移してしまった。
また、癌の初期や中期では、特別な症状がないことも多く、例えば、肺癌の場合、咳が出ることはあっても、明らかな吐血や深刻な呼吸困難がないため、何らかの煙を吸ったのではないか、アレルギーや気管支炎ではないか、などと考え、症状の確認を怠ることが多い。
症状があるから病院に検査に行き、医師はCTを勧めるが、患者は面倒に感じたり、費用がかかると感じたりして、通常のレントゲンを選択することが多い。通常のX線検査による腫瘍診断の感度は44~50%と非常に低く、CTによる骨転移診断の感度は71~100%、MRIの診断感度は82~100%、PET_CTによる腫瘍検出の感度は92%、特異度は99%に達し、これらのデータの違いは一目瞭然である。。

では、骨転移が起きていて進行期であれば、治療の必要はないというのは本当ですか?
もちろん、そんなことはない。患者の症状と生活の質を最大限に高める..正確な治療計画は、がんの種類、転移の場所と範囲、患者の全体的な健康状態によって異なります。そして、原発がんの治療が非常に重要であるようです。
骨転移を有する患者は、多くの場合、全身療法または局所療法で治療される..分割治療には、化学療法、分子標的治療、免疫療法、ホルモン療法などがあり、骨転移のある患者には、次のような薬剤も投与される。ビスフォスフォネート薬によって患部の骨が強くなり、再骨折や他の部位の骨折を予防することもできる。一方局所治療には、放射線治療、アブレーション、手術などがある。。
つまり、全体的な目的は、患者の苦痛を最小限に抑え、生存期間を延ばし、生活の質を向上させることである。
概要
つい先日、整形外科の同僚たちと話をしていたときのことだ。外来で癌性骨転移と診断される患者がますます増えていることは、私たち全員が言っていることですそして、私たちの身の回りには、あらゆる種類のがん患者がますます増えていると言えるが、なぜこのようなことが起こっているのだろうか?食事、遺伝子、環境、喫煙、飲酒、悪習慣など、要因は多岐にわたる。
がんによる骨転移患者の痛みには一定の特徴がありますが、一般的な病気と干渉する症状も見受けられます。もし患者が発生した場合、脊椎の骨転移が神経を刺激し、医師や患者が椎間板ヘルニアによって誘発された症状を誤診しやすく、この時、患者として、体に異常があるため、適時に医師の助けを求め、医師として患者とコミュニケーションを図り、比較的質の高い検査を行い、骨転移のリスクを除外しようとする。例えば、高齢者の長期的な腰痛に対しては、レントゲン検査の代わりにMRI検査を行うことをよく勧める。例えば、慢性的な腰痛を持つ高齢者に対しては、レントゲン検査の代わりにMRI(磁気共鳴画像装置)検査を受けるよう勧めることがよくあります。
また、40歳を過ぎたら1年に1回は人間ドックを受け、胃カメラと大腸カメラ、胸部検査を受けることが推奨されている。
上記は簡単な小科学の骨転移についてです。もし他に疑問があれば、以下にメッセージを残してください。
私は複雑な病気の知識を説明するために簡単な言語を使用することを主張する謝新輝です、それはコードを書くのは簡単ではありません、あなたは私の視点に同意する場合は、懸念を指摘したり、それを好きなようにクリックして助けてください、あなたやあなたの家族や友人もこの問題を抱えている場合は、それらの必要性にこの記事を転送してください、ありがとうございました!
骨転移はどのような痛みに注意すべきですか?骨転移は悪性腫瘍の末期によく見られる症状で、体の他の部位にある原発腫瘍が血液やリンパ液の経路を通って骨に転移し、骨転移を形成することを指します。骨転移は、正常な骨組織が破壊され、腫瘍組織に置き換わっていることを示す。骨転移は病変の特異性により、溶骨型、造骨型、混合型の3つに分類される。骨転移の好発部位は中軸骨(脊椎、骨盤)、肋骨、下部骨幹部で、特に中軸骨が最も多く、これはこの部位の血液供給の特徴と関係しています。下の円のように骨転移が多発し、脊椎の状態が悪い。

骨転移で起こる症状にはどのようなものがありますか?最初の症状は痛みです。骨転移を起こした部位は骨が破壊されるために痛みを感じますが、最初ははっきりした症状がなかったり、断続的な痛みだったりしますが、腫瘍が正常な骨をどんどん破壊して徐々に悪くなっていくため、転移部位の痛みも徐々に悪くなっていきます。臨床的には、体のある部分の骨の痛みで、悪性腫瘍の骨転移という症例に出くわすことがあります。以前、ある症例に出会ったのですが、40歳で、肩が痛く、五十肩かと思い、薬用オイルを数日揉んでも改善が見られず、ますます痛みが強くなったので、病院で検査をしたところ、MRIを撮ったところ、肩甲骨が(腫瘍の)かけらに食べられており、骨転移を考え、胸部CTを撮ったところ、右肺に結節があり、生検をして病理検査をしたところ、肺がんの骨転移でした。その内容は以下の通りである。

骨転移部位では、正常な骨組織が破壊され腫瘍組織に置き換わり、腫瘍細胞は常に増殖しているため、多くの骨転移部位で軟部組織の腫瘤影が見られ、腫瘤が表在する部位であれば触知することができる。また、腫瘍組織による正常な骨組織の侵食は、正常な骨構造の破壊と脆弱化につながるため、正常な外力下でも骨折が生じることがあり、病的骨折と呼ばれます(下図)。脊椎への転移は、疼痛や病的骨折に加えて、脊髄神経根の圧迫を伴い、感覚障害、筋力低下、場合によっては高カルシウム血症などの症状を呈することもあります。

臨床上、骨転移を起こしやすい悪性腫瘍には、乳がん、前立腺がん、肺がん、甲状腺がん、腎臓がんなどがあり、骨転移の原発腫瘍の約90%を占めていますので、上記のような腫瘍に罹患している方は、検査を受ける際に骨に異常がないかどうか注意する必要があります。骨転移の発生は腫瘍の進行期に属しますが、一部の患者さんの治療効果はまだかなり良好で、特に単純な骨転移の患者さんでは、総合的な治療によって比較的長い生存期間、あるいは腫瘍の長期生存を得られる患者さんも少なくありません。
私は@ShadowMedicineChoで、関連する医療についてもっと知るためにフォローすることができます。
私は泌尿器科に勤務しているため、仕事で前立腺がんに接することが多く、進行した前立腺がんで最初に現れるのが骨転移なので、骨転移の症状にはある程度詳しい。

この特殊な病気について知っておくべきことは以下の通りだ:
(i) 痛みの程度
日常生活での外傷による骨の損傷は、激しい痛みと局所の軟部組織の浮腫を引き起こし、明らかな外観と症状を呈する。筋緊張による局所的な痛みは疼痛であり、適切な安静によってすぐに緩和される。局所の感染症は、発赤、腫脹、熱感、疼痛といった典型的な症状を示し、明らかな圧痛を伴う。
しかし、骨転移によって引き起こされる痛みは、非常に特殊で、それほど激しい痛みではなく、私たちの本では「アントロポファジック(anthropophagic)」という痛みと表現されている。これは、わかりやすく言えば、小さな虫に刺されたような痛みという意味で、どのような姿勢をとっても緩和されない持続的な痛みである。これは非常に特殊なタイプの痛みで、私たちが生活の中で経験する組織損傷による痛みのほとんどとはまったく異なる。
(ii) 痛みの部位
骨転移の部位は通常、原発性癌病巣と関連しており、一般的に腫瘍からの距離が近いほど転移の確率は高くなる。乳癌は胸部にあるため、胸骨と肋骨の骨転移が最も多く、次いで脊椎の胸椎と腰椎、肺癌の骨転移では脊椎と四肢、腎臓癌と頸癌の転移では腰椎と骨盤の転移が最も多く、前立腺癌の転移では脊椎全体と四肢が転移部位となる。
背骨は血流が豊富なため、ほとんどのがん転移の第一選択となる。 背中やその他の部位に持続的な「蟻地獄のような」痛みがあり、がんの既往歴や家族歴がある場合は、警戒が必要である。

(iii) 診断方法
がんの既往歴がなく、家計に余裕がある患者には、全身にがんの疑わしい病変がないかスクリーニングするためにPET-CT検査を行うことが推奨され、これにより腫瘍病変の有無、進行度、どのような転移病巣があるかなどを適切に判断することができる。
がんの既往があり、その時点で悪性度が高いと判断されれば、全身骨シンチで骨転移の有無を調べることができる。同時に、転移部位の骨破壊の程度を磁気共鳴検査で明らかにすることができる。

(iv) 治療方法
なぜなら、骨髄腔はさまざまな種類の細胞が着床して増殖するのに適した環境だからである。一方、体の他の部位では、接着して増殖するためには、同じような種類の組織表面を見つける必要がある。
骨髄腔内のがん細胞も原発性がん病巣の細胞と同種であるため、治療の対象は骨転移ではなく、損失とも言える原発性がん病巣となる。原発巣の進行が抑えられれば、骨転移も抑えられる。
もちろん、少数の骨転移であれば、局所放射線治療で腫瘍を消失させることは可能である。

(v) 骨転移の合併症にはどのようなものがありますか?
骨転移は深刻な骨破壊を引き起こし、持続的な痛みをもたらし、生活の質に深刻な影響を及ぼし、後期には長期の鎮痛剤治療が必要となる。背骨が腫瘍によって圧迫されると、下肢の麻痺や排尿不能など、対麻痺に似た症状が出ることさえある。
骨転移部位の骨はすでに非常にもろいので、脊椎の圧迫骨折、手足や肋骨の骨折など、さまざまな程度の骨折を起こしやすい。ある時、整形外科で骨の一部がビスケットのようにもろくなっているのが見つかり、当科を呼んで診察してもらったところ、最終的に前立腺がんの骨転移と診断されました。
骨転移がある程度まで進行すると、骨髄造血が徐々に失われ、持続的かつ不可逆的な悪性貧血として現れ、患者は次第に毎月の定期的な輸血に頼らざるを得なくなり、数カ月間生命を維持することができなくなる。

結語
骨転移はそれ自体が病気を引き起こすわけではないが、骨転移がもたらす病気の苦しみは長期にわたる。
骨転移は、がんが進行したことを示すサインでもある。 原発病巣の成長を抑えることができれば、骨転移の発生を抑えることができるが、そうでなければ、次の段階として悪性貧血が出現し、生存期間はそれほど長くはない。
私は今でも、すべてのがん患者が早期診断と早期治療を受け、正直なところ、患者も家族も苦しむような状態にならないことを祈っている。
もし、あなたが私の意見に同意してくれるなら、「気になる」をクリックするか、「いいね!」を押してください。もし、あなたやあなたの家族や友人が、関連する知識を知る必要があるなら、この記事を必要な人に転送してください!
Dr.シャドウです。骨転移とは、がんが進行した状態のことで、がん細胞が血流にのって骨に転移し、骨に定着・増殖することで、溶骨性骨破壊や骨芽細胞性骨密度増加を引き起こします。腰痛や下肢痛のために進行した肺がんが発見されるがん患者が多いのは残念なことです。
がんの骨転移に注意すべき時期は?
1.持続的な骨痛を伴うがんの既往歴
原発性がんの既往があり、骨の特定の部位に持続的な痛みがある場合は、骨転移の可能性に注意する。
例えば、肺がんで胸や背中の痛みがしばらく続き、悪化する傾向がある場合は、骨転移の可能性を警戒する必要があります。この時、骨に異常がないかCTを撮る必要があります。CTで問題がなければ、転移がないとは断定できません。早期のCTでは骨転移がわからないため、ECTやPETCTを行うことで、従来の骨転移の発見よりも2~3ヶ月早く、骨転移病変を発見することができます。
2.病的骨折の発生
骨転移は骨を破壊するため、骨がもろくなり骨折しやすくなります。局所的な痛みだけでなく、ちょっと触れただけで骨折が起こり、痛みが悪化することもある。
3.限局性軟部組織腫瘤
骨転移は骨が蝕まれ、がん細胞が局所的に増殖して軟部組織の塊となり、これもがんの巣となります。痛みに加えてしこりを感じるのはそのためで、骨転移にも注意が必要です。
がんの既往がなくても、上記のような症状を伴う骨転移がある可能性はある。
46歳の男性が、腰の持続的な痛みのために受診した症例があった。腰痛は椎間板ヘルニアと考えられた。レントゲンを撮ったが異常は見られなかった。わずかな骨破壊を起こす骨転移はレントゲンでは見えないし、椎間板ヘルニアもレントゲンでは見えない。だから、転移の可能性については特に考えなかった。1週間後、それでも改善が見られないのでCTを撮りに来たところ、腰椎が食べられていた。 このような画像を見て、画像診断医は転移の可能性を考えるに違いないと思い、胸部CT検査をするよう患者に勧めたところ、案の定、肺に腫瘤があり、肺がんの骨転移と考えられ、後日病理検査で確認された。
その他、最初の症状が骨転移で、癌が進行していることが判明するケースも多い。骨転移を起こしやすいがんには、前立腺がん、肺がん、乳がん、大腸がんなどがあります。原発がんの既往の有無にかかわらず、少しでも違和感を覚えたら、速やかに通常の病院へ行きましょう。
私はそうだ。ドクター・シャドウ医療についてもっと知りたい方は、ぜひフォローしてください。
骨の痛みは、何らかの癌が発生した場合、治療済み、未治療にかかわらず、その後、骨の痛み、特に昼夜を問わず固定した部位の痛みは、通常の鎮痛剤では効果がなく、特に脊椎に多い。
例えば進行乳癌では、骨転移の発生率は非常に高く、骨格への初回転移は患者の27~50%に起こる。脊椎が最も多く、約半数を占める。次いで肋骨、骨盤、頭蓋骨、上腕骨、大腿骨、脛骨、腓骨、肩甲骨と続く。
疼痛は骨転移のほとんど(80%以上)の初期症状であり、一部の転移は非常に若年で発現する。骨痛、骨折、アルカリホスファターゼ上昇、高カルシウム血症などの骨転移が疑われる乳癌に対しては、骨放射性核種スキャン(ECT)を行うことができる。PET/CTはECTと同程度の感度で特異度が高く、乳がん骨転移の治療後の経過観察に使えるという研究もあります。診断が困難な場合は、必要に応じて骨の一部を切除して病理検査を行うこともある。
乳がんの骨転移で最も多い合併症は骨関連事象(SRE)ですが、SREとは何ですか?
骨痛の増悪や新たな骨痛の出現、病的骨折、椎骨の圧迫や変形、脊髄圧迫、骨放射線治療後の症状、高カルシウム血症などである。乳癌の骨転移は "骨関連事象 "を特徴とし、患者の自立活動やQOLに深刻な影響を与えることが多いが、骨転移自体は一般的に患者の生命を直接脅かすものではなく、内臓転移がなければ生存期間は比較的長い。



私は骨転移の患者です!このような悪性腫瘍に罹患した患者は、骨転移を予防すべきだと思います!というのも、悪性腫瘍は治療されているようですが.
しかし、癌細胞は狡猾だ。血流の中に隠れてしまう。いつでも行ける場所を見つける!例えば、私!治療後
しばらく胸の痛みが続いている。しかも痛みは一箇所に固定されている。痛みがひどくて、食事もとれないし、よく眠れない。とてもイライラしていました。それで病院に行って診察を受けました。
医師は、表面上はすべて正常で、そうでなければCT検査を受けるべきだと言った。その後、CTを撮ったのですが、その結果はすべて正常でした!それなら仕方がない。家に帰った。
そして彼はまた痛まなくなった。あと3ヵ月。この癌は毎年大きな検査を受けなければならないからだ。医師は私にCT検査をするように言った。私はそう言った。
強化CTを撮るべきだと言われ、そうしました。骨転移かどうかを判断するためにね。骨スキャンとMRIをしました。骨転移と判断された!だから、一カ所に固定され、半月以上痛みが続いている人は、病院に行って検査したほうがいい!
骨転移がんの話をすると、私が研修医だったころの患者さんのことを思い出します。その患者さんは巨大な肝臓がんの患者さんだったのですが、当時、私と指導医が肝臓がんの切除を成功させたのは、その患者さんの頭部に小さな腫瘍があったためで、肝臓の手術が終わったら、ついでに頭部の小さな腫瘍も切除してしまおうと、手術前に患者さんに話していたのです。頭の小さな腫瘍を切ってみると、腫瘍はどんどん深く切り込まれ、白い脳組織とその周囲に虫食い状に損傷した頭蓋骨が見えたので、怖くなり、あわてて上の医師に伝えると、すぐに頭蓋脳外科の専門医が来て対処してくれた。この症例で、私は初めてがんの骨転移という病気を理解した。

骨転移の磁気共鳴画像法
骨転移は、転移性骨腫瘍とも呼ばれる。骨以外の臓器や組織から発生した悪性腫瘍が、血液やリンパ液の移動によって骨に転移し、増殖を続けることでできる骨の転移性がんを指します。
がん患者には骨転移がんを発症するパターンがまだある:
- 骨転移を起こしやすい中高年がん患者は、40~60歳代に多い。
- 骨転移を起こす癌のほとんどは中期から末期の癌で、進行癌であればあるほど骨転移を起こす可能性が高くなります。
- がんの分化度が低く悪性度が高いほど、骨への転移リスクが高くなる。
- 骨転移癌の相対リスクは癌によって異なる。骨転移癌のリスクでは、乳癌>前立腺癌>甲状腺癌>肺癌である。
- 癌患者の骨転移は、比較的好発部位が多い。脊椎>骨盤>下肢の長骨、肋骨>頭蓋骨>上肢の長骨である。

がんの骨転移の好発部位
以上のパターンを把握することで、骨転移がんのリスクを早期検査で発見することができる。また、上記の骨転移の特徴を把握することで、対応する骨の部位に痛みがあれば、骨転移がんのリスクを見つけることができる。
骨転移がんには特有の臨床症状があり、骨転移のリスクを早期に発見するのにも役立つ。
転移性骨癌の主な症状は、疼痛、腫脹、病的骨折、脊髄圧迫であり、疼痛が最も一般的である。骨転移癌患者の痛みは、初期にはほとんど間欠的である。骨転移がん患者の痛みは、初期段階ではほとんどが間欠的で、つまり、痛いときと痛くないときがあり、時間の経過とともに痛みは深刻になり、持続時間も長くなります。また、夜間に痛みが悪化する患者も多い。また、骨転移性がんで出現する痛みは、体位を変えてもあまり軽減しないという事実もあります。また、一般的な骨・関節疾患の痛みには有効な理学療法、鍼灸治療、漢方薬の外用などは、骨転移性癌患者の痛みには効果がないことが多く、鎮痛剤でも痛みを和らげることができないこともあります。

胸椎に発生した骨転移性癌を示す。
血液検査で血中カルシウムの異常上昇、血清アルカリホスファターゼの異常上昇、酸性ホスファターゼの異常上昇があれば、骨転移がんのリスクを考慮すべきである。
溶骨性、造骨性、混合性骨破壊のX線所見も、転移性骨癌の可能性を考慮すべきである。転移性骨腫瘍を検出するには、適時の骨スキャンが感度の高い方法である。
骨転移がんが発見された場合、標的治療は非常に重要である。
原発がんと骨転移がんを同時に根治切除できるがん患者はごくわずかである。骨転移癌患者のほとんどは、通常、患者の延命、痛みの緩和、QOLの向上を目的とした緩和ケアを受ける。化学療法、放射線療法、内分泌療法は、原発性がんと転移性がんの両方の治療に用いられる。
骨転移とは、体の他の部位にある腫瘍細胞が骨膜に植わって癌を形成することを指し、二次性骨転移癌とも呼ばれる。現在、男性では腎臓がん、膵臓がん、直腸がん、胃がん、甲状腺がん、肺がん、前立腺がん、女性では乳がん、卵巣がんなどが骨転移を起こしやすいことが分かっています。したがって、上記のようながんが発生した場合は、骨転移に注意し、必要に応じて定期的な検査を受ける必要がある。骨シンチなどをチェックする。

骨転移を警告すべき痛みとはどのようなものですか?
原発巣から骨膜に転移したがん細胞は、骨膜だけでなく骨組織も破壊しながら異常増殖を続ける。初期の骨痛の場合、人体は通常鈍い痛みを感じ、その局在は不正確であることが多い(簡単に言えば、ある部分の痛みしかわからないが、それが具体的にどの位置なのかを正確に指摘することができない)。骨転移が骨に深刻なダメージを与えると、痛みは明らかで、我慢できず、夜も眠れなくなり、痛みを和らげるためにオピオイド受容体の鎮痛剤(オキシコドン塩酸塩錠、モルヒネ・オキシコドン錠など)を服用する必要があります。骨転移の中には病的骨折を起こすものもある。そのため、がん患者が突然骨の痛みや違和感を自覚した場合は、骨転移に注意する必要がある。X線フィルム、全身骨スキャン画像(ECTとも呼ばれる)、CTなどをチェックして、状態をはっきりさせることができます。骨転移があれば、ゾレドロン酸やパミドロン酸二ナトリウムなどのビスフォスフォネート製剤を適切に注入します。

がんについてどう考えていますか?
医療技術の進歩に伴い、現在のがん治療法には元来の単剤化学療法と放射線療法があり、徐々に標的療法、免疫療法、定位放射線療法、遺伝子編集療法など様々な手段に発展し、がん患者の生存期間を大幅に延長している。がん患者は前向きな気持ちでこの病気に立ち向かい、積極的に治療に協力すべきである。
私の答えがあなたのお役に立てれば幸いです!もし気に入っていただけたら、「いいね!」をお願いします!

この質問と回答はサイト利用者のものであり、サイトの立場を代表するものではありません、侵害など、削除するには管理者に連絡してください。